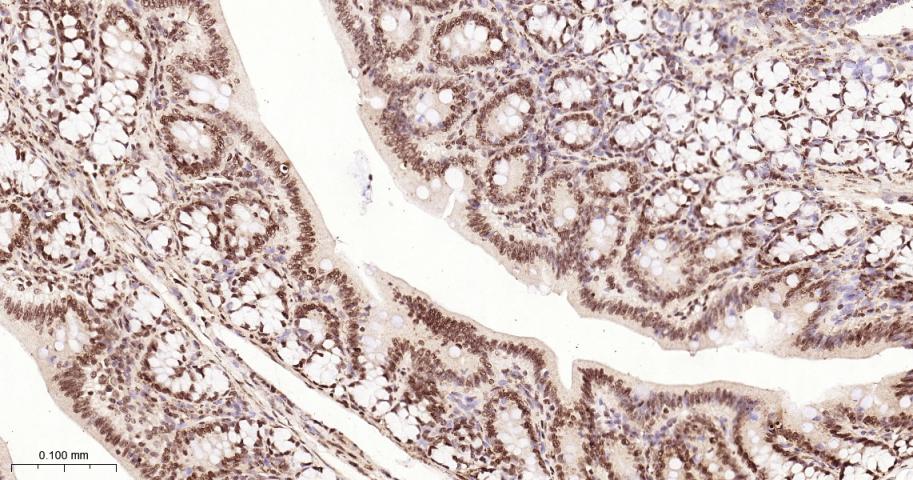
组蛋白H2A重组兔单抗

组蛋白H2A重组兔单抗
Rrmab?兔单抗

货号:bsm-63133R
产品详情
相关标记
相关产品
相关文献
常见问题
概述
产品编号
bsm-63133R
产品类型
重组兔单抗
英文名称
Histone H2A Recombinant Rabbit mAb
中文名称
组蛋白H2A重组兔单抗
英文别名
H2A.1; H2A.2; H2A/a; H2AC4; H2AFA; HIST1H2AE; H2AB; HIST2H2AB; H2A/m; H2AC8; H2AFM; HIST1H2AB; H2A; H2A-GL101; H2A/q; H2AFQ; HIST2H2AC; 1190022L06; H2A1B_HUMAN; Histone H2A.2; Histone H2A/a; Histone H2A/m; H2A1_HUMAN; H2AC11; H2AC13; H2AC15; H2AC16; H2AC17; Histone H2A/ptl; H2AFP; HIST1H2AG; H2AFC; HIST1H2AI; H2AFD; HIST1H2AK; H2AFI; HIST1H2AL; H2AFN; HIST1H2AM; H2A1D_HUMAN; H2AC7; Histone H2A.3; Histone H2A/g; H2AFG; HIST1H2AD; H2A2C_HUMAN; H2AC20; H2A-clustered histone 20; Histone H2A-GL101; Histone H2A/q; H2A2A_HUMAN; H2AC18; H2AC19; H2A-clustered histone 18; H2A-clustered histone 19; Histone H2A/o; H2AFO; HIST2H2AA; HIST2H2AA3; HIST2H2AA4; H2A3_HUMAN; H2AC25; H2A-clustered histone 25; H2AW; HIST3H2A; H2A2B_HUMAN; H2AC21; H2A-clustered histone 21; H2A1C_HUMAN; H2AC6; H2A-clustered histone 6; Histone H2A/l; H2AFL; HIST1H2AC; H2A1H_HUMAN; H2AC12; H2A-clustered histone 12; Histone H2A/s; HIST1H2AH; H2A1A_HUMAN; H2AC1; H2A-clustered histone 1; Histone H2A/r; H2AFR; HIST1H2AA; H2A1J_HUMAN; H2AC14; Histone H2A/e; H2AFE; HIST1H2AJ; H2A4_MOUSE; H2A1_MOUSE;
抗体来源
Rabbit
免疫原
A synthesized peptide derived from human Histone H2A: 70-100
亚型
IgG
性状
Liquid
纯化方法
affinity purified by Protein A
克隆类型
Recombinant
克隆号
2F12
理论分子量
14 kDa
检测分子量
14 kDa
储存液
10mM phosphate buffered saline(pH 7.4) with 150mM sodium chloride, 0.05% BSA, 0.02% Proclin300 and 50% glycerol.
SWISS
Gene ID
保存条件
Store at 4℃ for short term. Store at -20℃ for long term. Avoid repeated freeze/thaw cycles.
注意事项
This product as supplied is intended for research use only, not for use in human, therapeutic or diagnostic applications.
数据库链接
背景资料
Core component of nucleosome. Nucleosomes wrap and compact DNA into chromatin, limiting DNA accessibility to the cellular machineries which require DNA as a template. Histones thereby play a central role in transcription regulation, DNA repair, DNA replication and chromosomal stability.

产品应用
| 应用 | 已检合格种属 | 预测种属 | 推荐稀释比例 |
|---|---|---|---|
| WB | Human, Mouse, Rat | 1:500-2000 | |
| IHC-P | Human, Mouse, Rat | 1:100-500 | |
| IHC-F | Human, Mouse, Rat | 1:100-500 | |
| IF | Human, Mouse, Rat | 1:100-500 | |
| ICC/IF | Human, Mouse, Rat | 1:50-200 |
交叉反应
交叉反应: Human, Mouse, Rat
相关产品
暂无相关产品
靶标
基因名
H2AC4
蛋白名
Histone H2A type 1-B/E
亚基
The nucleosome is a histone octamer containing two molecules each of H2A, H2B, H3 and H4 assembled in one H3-H4 heterotetramer and two H2A-H2B heterodimers. The octamer wraps approximately 147 bp of DNA.
亚细胞定位
Nucleus. Chromosome.
组织特异性
Abundant expression is seen in the skeletal muscle. It is also widely expressed in other tissues.
翻译后修饰
The chromatin-associated form is phosphorylated on Thr-121 during mitosis (Probable).
Deiminated on Arg-4 in granulocytes upon calcium entry.
Monoubiquitination of Lys-120 by RING1 and RNF2/RING2 complex gives a specific tag for epigenetic transcriptional repression and participates in X chromosome inactivation of female mammals. It is involved in the initiation of both imprinted and random X inactivation. Ubiquitinated H2A is enriched in inactive X chromosome chromatin. Ubiquitination of H2A functions downstream of methylation of 'Lys-27' of histone H3. Monoubiquitination of Lys-120 by RNF2/RING2 can also be induced by ultraviolet and may be involved in DNA repair. Following DNA double-strand breaks (DSBs), it is ubiquitinated through 'Lys-63' linkage of ubiquitin moieties by the E2 ligase UBE2N and the E3 ligases RNF8 and RNF168, leading to the recruitment of repair proteins to sites of DNA damage. Monoubiquitination and ionizing radiation-induced 'Lys-63'-linked ubiquitination are distinct events.
Phosphorylation on Ser-2 is enhanced during mitosis. Phosphorylation on Ser-2 by RPS6KA5/MSK1 directly represses transcription. Acetylation of H3 inhibits Ser-2 phosphorylation by RPS6KA5/MSK1.
Symmetric dimethylation on Arg-4 by the PRDM1/PRMT5 complex may play a crucial role in the germ-cell lineage.
Deiminated on Arg-4 in granulocytes upon calcium entry.
Monoubiquitination of Lys-120 by RING1 and RNF2/RING2 complex gives a specific tag for epigenetic transcriptional repression and participates in X chromosome inactivation of female mammals. It is involved in the initiation of both imprinted and random X inactivation. Ubiquitinated H2A is enriched in inactive X chromosome chromatin. Ubiquitination of H2A functions downstream of methylation of 'Lys-27' of histone H3. Monoubiquitination of Lys-120 by RNF2/RING2 can also be induced by ultraviolet and may be involved in DNA repair. Following DNA double-strand breaks (DSBs), it is ubiquitinated through 'Lys-63' linkage of ubiquitin moieties by the E2 ligase UBE2N and the E3 ligases RNF8 and RNF168, leading to the recruitment of repair proteins to sites of DNA damage. Monoubiquitination and ionizing radiation-induced 'Lys-63'-linked ubiquitination are distinct events.
Phosphorylation on Ser-2 is enhanced during mitosis. Phosphorylation on Ser-2 by RPS6KA5/MSK1 directly represses transcription. Acetylation of H3 inhibits Ser-2 phosphorylation by RPS6KA5/MSK1.
Symmetric dimethylation on Arg-4 by the PRDM1/PRMT5 complex may play a crucial role in the germ-cell lineage.
相似性
Belongs to the histone H2A family.
功能
Core component of nucleosome. Nucleosomes wrap and compact DNA into chromatin, limiting DNA accessibility to the cellular machineries which require DNA as a template. Histones thereby play a central role in transcription regulation, DNA repair, DNA replication and chromosomal stability. DNA accessibility is regulated via a complex set of post-translational modifications of histones, also called histone code, and nucleosome remodeling.
标记抗体
暂无标记数据
同靶标产品
暂无同靶标产品
相关文献
提示: 发表研究结果有使用 bsm-63133R 时请让我们知道,以便我们可以引用参考文章。作为回馈,资料提供者将获得我们送上的小礼品。
暂无相关文献
常见问题
暂无常见问题